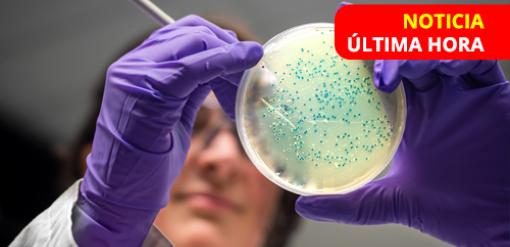

Noticias
Estás aquí
Contáctanos
Una nueva generación de terapias comienza a transformar el panorama del Alzheimer, el anticuerpo monoclonal donanemab demostró en un estudio de extensión de fase 3 que, cuando se administra en etapas tempranas de la enfermedad, reduce en 27% el riesgo de progresar a fases más avanzadas y logra la eliminación de placas amiloides en más del 75% de los pacientes durante las primeras 76 semanas.
Una empresa china ha utilizado la herramienta CRISPR para modificar genéticamente un cerdo de la raza Bama Xiang. La compañía empleó una técnica que consiste en insertar tres genes humanos y silenciar tres genes porcinos, con el objetivo de evitar el rechazo del órgano; el cerdo donante se crio en condiciones estrictas de bioseguridad, para impedir su contacto con patógenos y los resultados de la cirugía realizada se revelan en la revista especializada Nature Medicine.
Los científicos han utilizado la inteligencia artificial para crear posibles nuevos fármacos contra las llamadas superbacterias. En los últimos años la IA ha dado un nuevo giro al descubrimiento de fármacos, ayudando a investigadores a identificar tratamientos prometedores
Desde el Centro de Medicina de Desastres y Traumatología y la Universidad de Linköping, un equipo sueco desarrolló una biotinta de hidrogel granular bifásica y bioimprimible, esta innovación permite fabricar secciones de gel con una concentración celular muy alta, gracias a estos fragmentos tridimensionales que se insertan en la piel, el equipo podría regenerar la dermis de heridas profundas sin dejar cicatrices relevantes.
Un estudio de la Universidad de Cambridge analizó los datos de 51 informes que abarcaban a casi 30 millones de personas y encontraron fuertes vínculos entre los riesgos de demencia y la exposición a partículas finas procedentes de fuentes como las emisiones de los coches, las centrales eléctricas, así como al dióxido de nitrógeno procedente de la quema de combustibles y al hollín de los coches y de la quema de madera.
Un brote de Rickettsia ha encendido las alarmas sanitarias en México, con 183 casos confirmados y 40 muertes registradas hasta la semana epidemiológica 27, que abarca del 19 junio - 5 de julio 2025, según la Secretaría de Salud del Estado de Sonora.
Un nuevo estudio publicado en la revista The Lancet calcula el impacto de la resistencia a los antibacterianos en las próximas décadas, revelando que podría matar a casi dos millones de personas al año desde 2050.
Un estudio publicado por la revista científica Food Science & Nutrition y realizado por la Wenzhou Medical University ha encontrado una relación genética entre el consumo frecuente de café instantáneo y un mayor riesgo de desarrollar degeneración macular seca relacionada con la edad (DMAE), una de las principales causas de ceguera irreversible en adultos mayores.
Esta nueva técnica fue publicada en la revista Science por un equipo de científicos estadounidenses, la investigación demostró que una reprogramación inmunitaria rápida y sostenida en modelos animales es útil y dio resultados positivos, lo que la convierte en una terapia prometedora contra el cáncer y enfermedades autoinmunes.